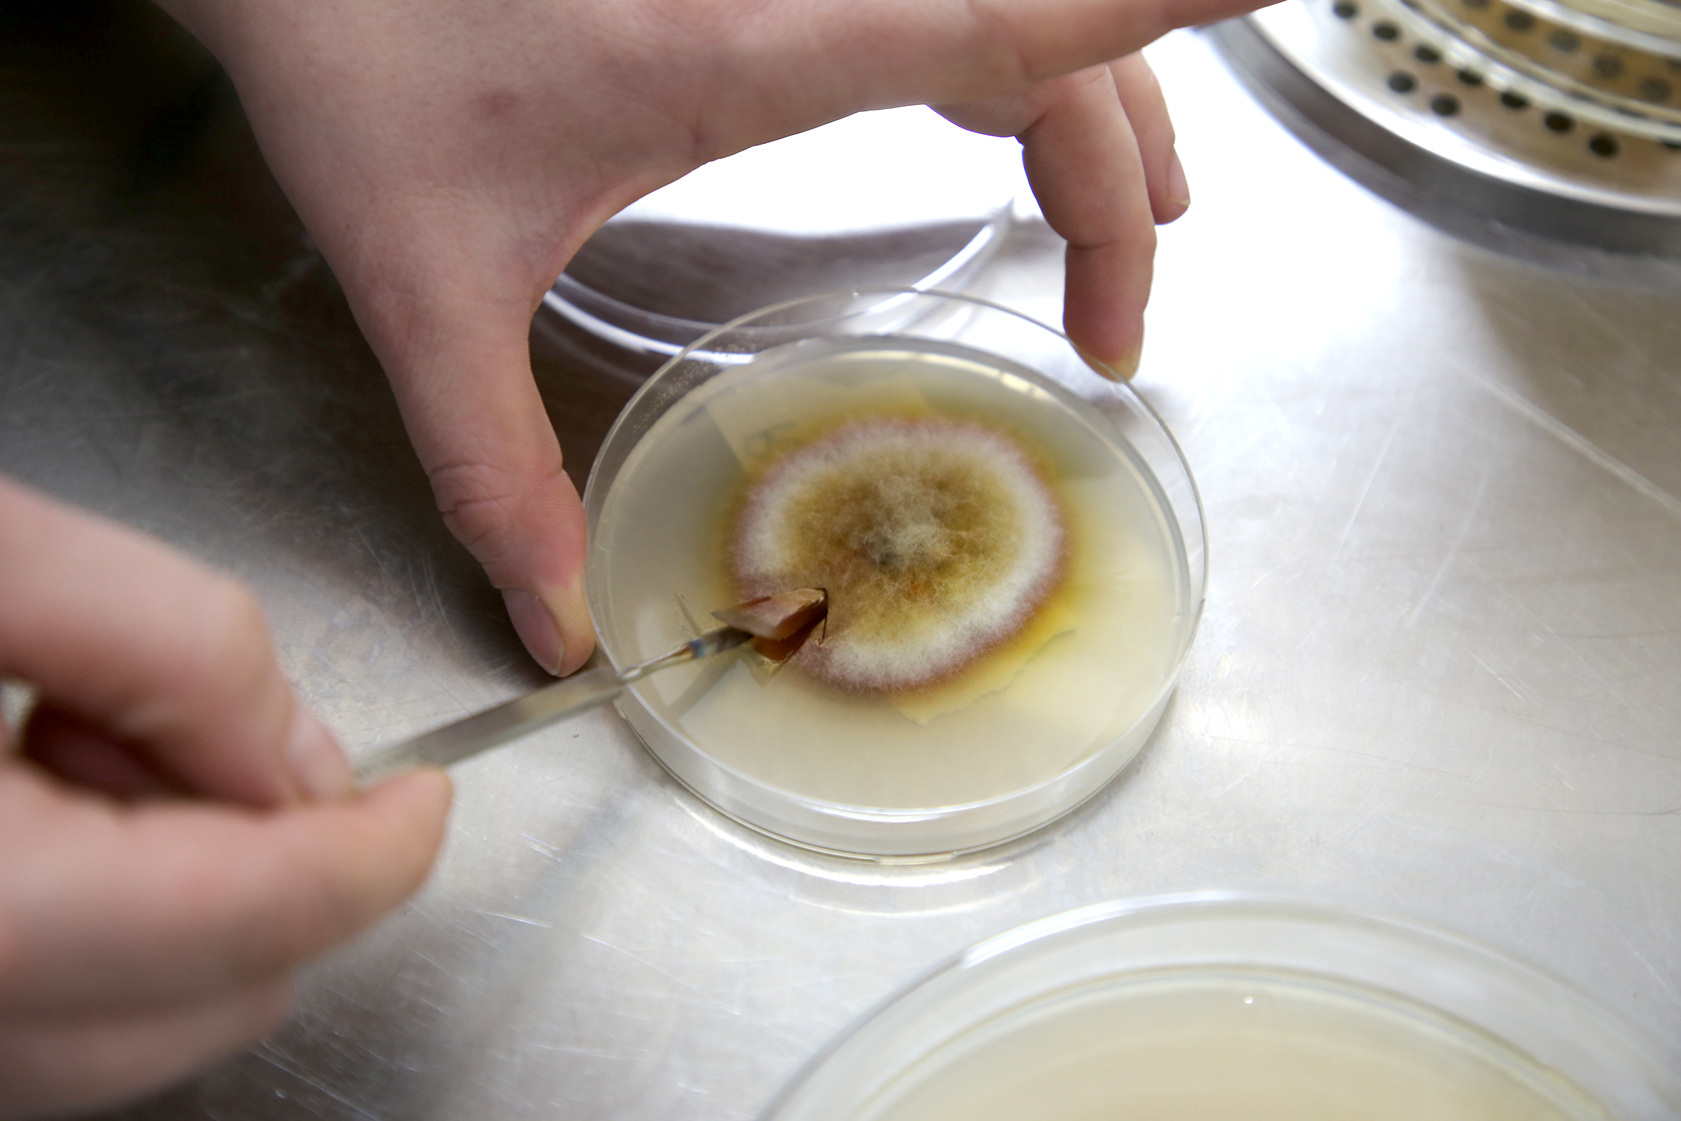

Pilzworkshop
SoSe 2018 - Workshop



“Pilze bilden eine unbeachtete Mehrheit im gemeinsamen Habitat. Durch ihre Zersetzungsprozesse stellen sie verschlossene Ressourcen wieder für Pflanzen und Tiere bereit. Ihre enzymatischen Prozesse können sogar dabei helfen vom Menschen verursachte Umweltkatastrophen zu bereinigen. Die jungen Disziplinen Bio-Art und Bio-Design verlagern die Forschung an Pilzen in den Bereich der Kunst und Gestaltung. Der angestrebte Workshop vermittelt interessierten Studierenden aus dem Bereich Produkt-Design, Visuelle Kommunikation und Bildender Kunst die Grundlagen, um mit Pilzpartnern zu kollaborieren. Neben technischen Grundlagen zur Pilzzucht werden zeitgenössische Positionen aus der Bio-Art und dem Bio-Design vorgestellt und kritisch diskutiert. Das Ziel des Kurses ist es den Studierenden einen ersten Ein- und Überblick in die Thematik zu verschaffen. Er soll die Basis schaffen auf welcher die Studierenden selbständige gestalterisch-künstlerische Ideen entwickeln.”